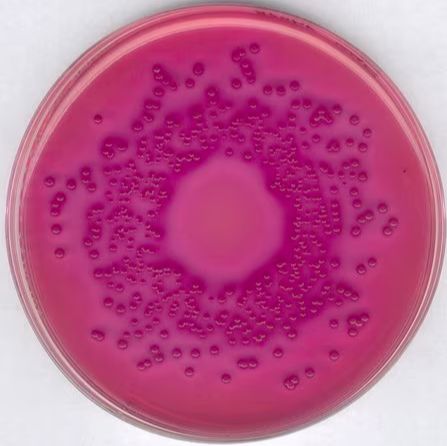
产品封面图

相关产品推荐更多 >
万千商家帮你免费找货
0 人在求购买到急需产品
- 详细信息
- 技术资料
- 库存:
999
- 保修期:
可咨询
- 现货状态:
可咨询
- 供应商:
默克
- 规格:
1.10275.0500
一般描述
紫红色胆汁葡萄糖琼脂是一种颗粒状选择性培养基,推荐用于检测和计数肠杆菌科细菌,尤其是来自非无菌产品和药物制剂的胆汁耐受革兰氏阴性菌。颗粒可确保在水中快速均匀地溶解,防止培养基结块和吸入空气中的粉末。明胶和酵母提取物的胰酶消化物提供了细菌代谢所必需的含氮化合物和其他营养素。由于存在抑制剂、胆汁盐和结晶紫,因此该培养基具有选择性。结晶紫抑制革兰氏阳性生物。中性红指示剂有助于检测葡萄糖发酵。葡萄糖发酵菌株在中性红存在下产生带有粉红色-红色光晕的红色菌落。氯化钠维持培养基中的渗透平衡。
应用
推荐使用紫红色胆汁葡萄糖琼脂检测和计数药品中的肠杆菌科细菌。

风险提示:丁香通仅作为第三方平台,为商家信息发布提供平台空间。用户咨询产品时请注意保护个人信息及财产安全,合理判断,谨慎选购商品,商家和用户对交易行为负责。对于医疗器械类产品,请先查证核实企业经营资质和医疗器械产品注册证情况。
 技术资料
技术资料暂无技术资料 索取技术资料
1.10275.0500 Merck 默克 GranuCult VRBD(紫红胆汁葡萄糖)琼脂
¥1581.42